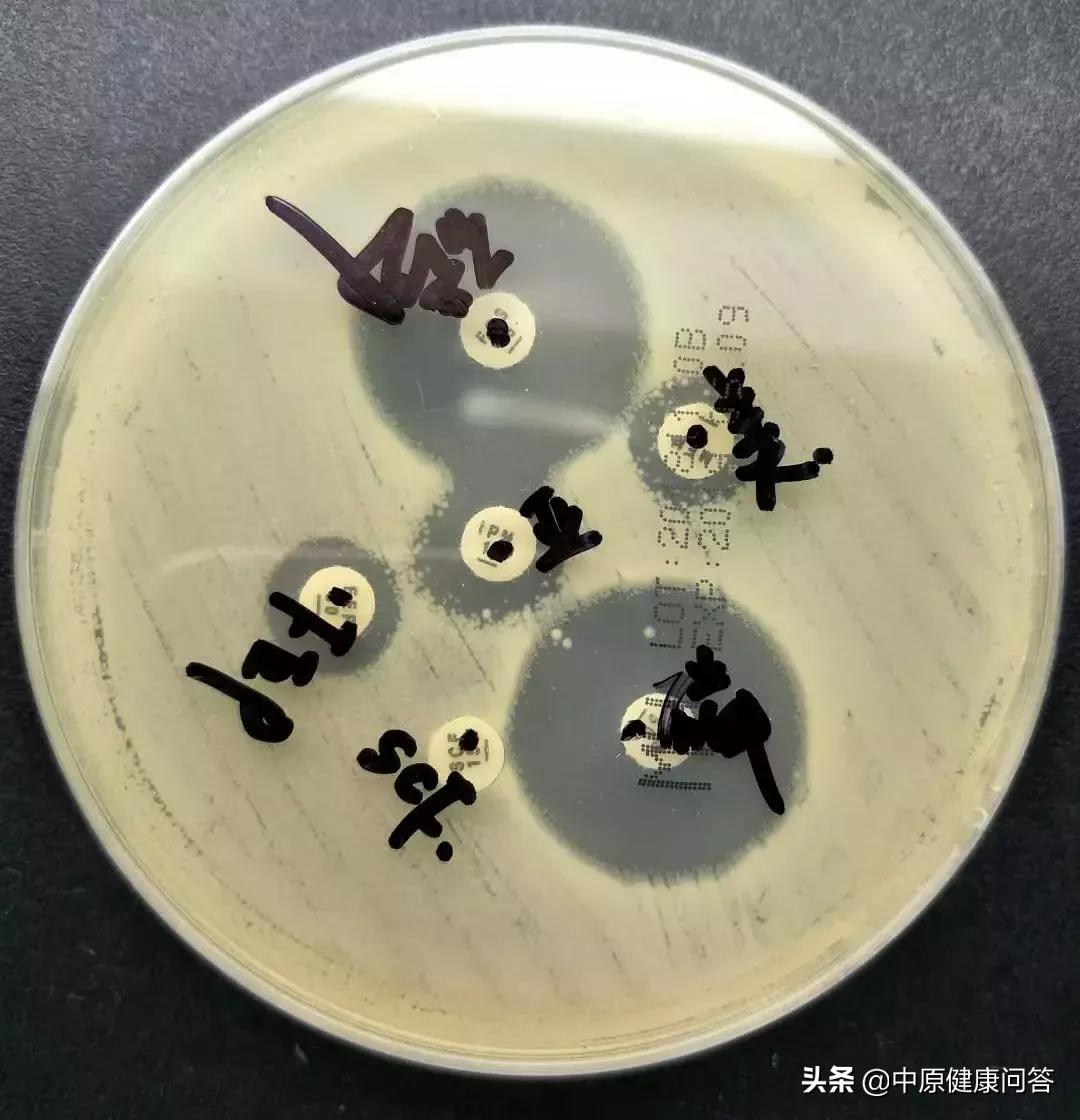
孩子一出生就进重症监护室,刚出生的婴儿在重症监护室9天

临近春节,
怀胎十月的我即将分娩,
新生命的降临,
为我们一家带来无限的惊喜与感动,
但是……
“出生10分钟,
我的宝宝就进了新生儿重症监护室”

在孕31周的时候,由于孕期糖尿病,宝宝突然提前到来了,郑州市中心医院产科医护人员竭尽全力,帮助我产下宝宝,但由于早产,孩子存在新生儿呼吸窘迫,为了更好地治疗,孩子立马被送进了新生儿重症监护室。
体重1.66kg,
伴有呼吸困难、
重症肺炎、
呼吸衰竭
……
第二次气管插管辅助呼吸
宝宝送检的痰细菌培养出了超级细菌——耐碳青霉烯类肺炎克雷伯菌CR-kp。
这种病菌致病力强,毒力大,治疗棘手,如果不能有效控制,宝宝也许就……
新生儿重症监护室主任王凯
马上联系医院感染性疾病MDT会诊!
上午11点,RICU主任高延秋、EICU主任王宝玉、感染性疾病科主任贾满仓、院感科主任秦红英,放射科主任医师张欣,检验科微生物室张艺,药学科谭然及秘书李双凤、院感科郭磊磊等成员齐聚新生儿科,对宝宝进行会诊。

现场听诊
观察患儿吸出痰液量及痰液外观
解读影像
讨论病情

但是,所有问题归结为一点:患儿出现重症肺炎呼吸衰竭,感染病原菌耐药性强,敏感药物不仅超级贵,并且肝肾毒性大,属于儿童禁忌药!
怎么办?
这时,RICU高延秋主任提出一个想法:做联合药敏试验!
就是将两种或三种不敏感的药物联合在一起,用不同组合的药物对致病菌抑菌圈的大小判断优劣,从而选择最佳的抗感染方案!
根据临床用药情况,微生物实验室张艺当天开始试验,第二天结果显示——这种方法可能有效!
王凯主任根据细菌联合药敏试验结果,调整用药方案、做好院感防护,经过共同努力,宝宝已经好转并成功拔管。

宝宝目前情况稳定,现已痊愈出院